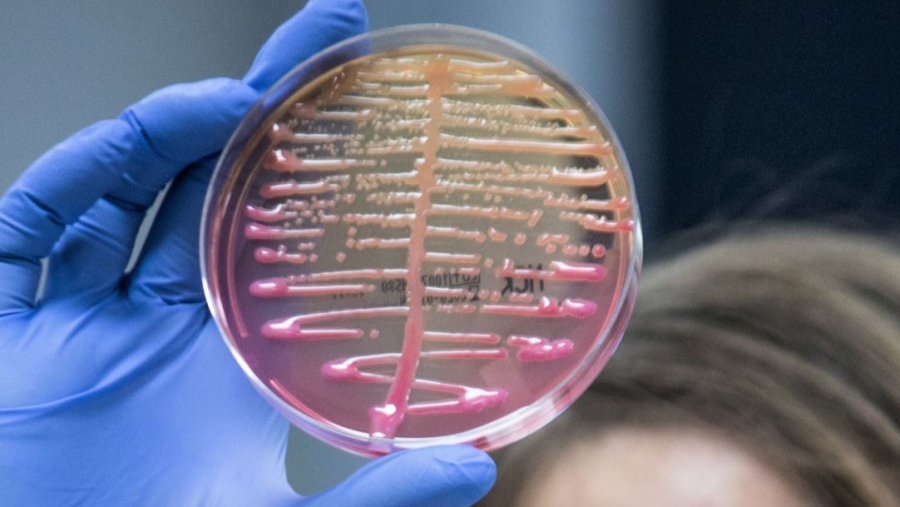

Το συγκεκριμένο βακτήριο προκαλεί ενδονοσοκομειακές λοιμώξεις, με επιπτώσεις όπως πνευμονία, ουρολοιμώξεις, καθώς και λοιμώξεις χειρουργικών τραυμάτων
Ανησυχία προκαλεί η διασπορά του ανθεκτικού βακτηρίου klebsiella pneumoniae σε ελληνικά νοσοκομεία.
Σύμφωνα με έκθεση του Ευρωπαϊκού Κέντρου Ελέγχου Νόσων (ECDC), από κοινή μελέτη του ΕΟΔΥ και του ΕCDC, η οποία πραγματοποιήθηκε σε δεκαπέντε ελληνικά νοσοκομεία, το 2022, διαπιστώθηκε ταχεία ενδονοσοκομειακή και διαπεριφερειακή εξάπλωση του συγκεκριμένου βακτηρίου, κατάσταση η οποία έχει, επίσης, τεκμηριωθεί σε άλλες χώρες της Ευρωπαϊκής Ενωσης.
Οι ειδικοί επιστήμονες επισημαίνουν ότι για την πρόληψη της μετάδοσης από ασθενή σε ασθενή του βακτηρίου klebsiella pneumoniae, πρέπει να λαμβάνονται αυστηρά μέτρα πρόληψης και ελέγχου των λοιμώξεων στα νοσοκομεία.
Το συγκεκριμένο βακτήριο προκαλεί ενδονοσοκομειακές λοιμώξεις, με επιπτώσεις (όπως πνευμονία, ουρολοιμώξεις, καθώς και λοιμώξεις χειρουργικών τραυμάτων) κυρίως σε ασθενείς με σοβαρές ασθένειες.
Η αλόγιστη κατανάλωση αντιβιοτικών, πέραν των κανόνων ορθής χρήσης τους και χωρίς οδηγίες από τους θεράποντες ιατρούς, συμβάλλει στην ανάπτυξη της αντοχής των μικροβίων απέναντι στα φάρμακα, ενώ αποτρεπτικά, για την ανάπτυξη νοσοκομειακών λοιμώξεων, λειτουργεί η σχολαστική τήρηση των κανόνων υγιεινής από την πλευρά του προσωπικού (π.χ. απολύμανση των χεριών ή αλλαγή γαντιών από ασθενή σε ασθενή, καθώς και ο καθαρισμός ιατρικών εργαλείων, όπως το στηθοσκόπιο κ.ά.).
www.bankingnews.gr
Σύμφωνα με έκθεση του Ευρωπαϊκού Κέντρου Ελέγχου Νόσων (ECDC), από κοινή μελέτη του ΕΟΔΥ και του ΕCDC, η οποία πραγματοποιήθηκε σε δεκαπέντε ελληνικά νοσοκομεία, το 2022, διαπιστώθηκε ταχεία ενδονοσοκομειακή και διαπεριφερειακή εξάπλωση του συγκεκριμένου βακτηρίου, κατάσταση η οποία έχει, επίσης, τεκμηριωθεί σε άλλες χώρες της Ευρωπαϊκής Ενωσης.
Οι ειδικοί επιστήμονες επισημαίνουν ότι για την πρόληψη της μετάδοσης από ασθενή σε ασθενή του βακτηρίου klebsiella pneumoniae, πρέπει να λαμβάνονται αυστηρά μέτρα πρόληψης και ελέγχου των λοιμώξεων στα νοσοκομεία.
Το συγκεκριμένο βακτήριο προκαλεί ενδονοσοκομειακές λοιμώξεις, με επιπτώσεις (όπως πνευμονία, ουρολοιμώξεις, καθώς και λοιμώξεις χειρουργικών τραυμάτων) κυρίως σε ασθενείς με σοβαρές ασθένειες.
Η αλόγιστη κατανάλωση αντιβιοτικών, πέραν των κανόνων ορθής χρήσης τους και χωρίς οδηγίες από τους θεράποντες ιατρούς, συμβάλλει στην ανάπτυξη της αντοχής των μικροβίων απέναντι στα φάρμακα, ενώ αποτρεπτικά, για την ανάπτυξη νοσοκομειακών λοιμώξεων, λειτουργεί η σχολαστική τήρηση των κανόνων υγιεινής από την πλευρά του προσωπικού (π.χ. απολύμανση των χεριών ή αλλαγή γαντιών από ασθενή σε ασθενή, καθώς και ο καθαρισμός ιατρικών εργαλείων, όπως το στηθοσκόπιο κ.ά.).
www.bankingnews.gr














Σχόλια αναγνωστών